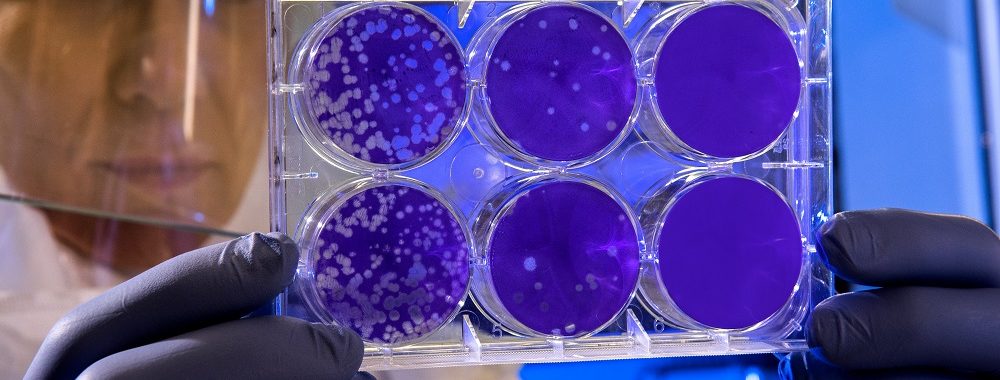

Le bilan ne cesse de s'alourdir depuis la découverte d'une nouvelle souche de coronavirus en Chine.
Selon les autorités sanitaires chinoises, 870 cas de pneumonie causée par le virus ont été confirmés à vendredi passé et 26 se sont avérés mortels. La situation a évolué fortement durant le weekend pour atteindre plus de 2700 cas dont 80 mortels. La majorité des victimes sont localisées dans la province du Hubei où se situe l’épicentre de l’épidémie. En dehors de la Chine, des personnes contaminées ont été signalées dans plusieurs pays, dont Singapour, Taïwan, la Corée du Sud, la Thaïlande, le Vietnam, mais aussi les États-Unis.
Les autorités ont confirmé que le nouveau coronavirus est transmissible d’humain à humain, mais de nombreuses incertitudes demeurent à l’heure actuelle, notamment sur le mode de transmission et les facteurs de risque associés. Ces vingt dernières années, deux épidémies mortelles de coronavirus ont touché l’Asie et le Moyen-Orient, causant au total le décès de plus de 1600 personnes.
L’épidémie de SRAS de 2002-2003 en Chine, dont le virus est très proche de la nouvelle souche identifiée, avait infecté plus de 8 000 personnes dans 26 pays, avec un taux de mortalité proche de 10%. À la veille du Nouvel an chinois, les autorités chinoises craignent une intensification de la propagation du virus en raison du chassé-croisé massif prévu dans les transports du pays.

Vous trouverez plus d’infographies sur Statista